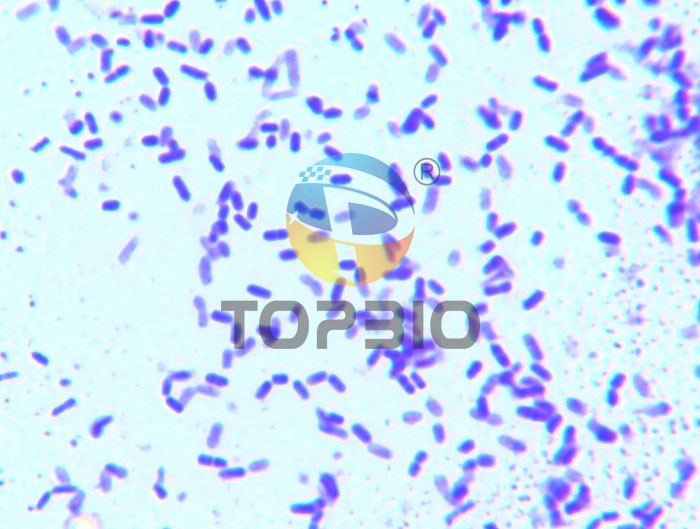
@΢RRzƬ

- 定做培養(yǎng)基/定制培養(yǎng)基
- 顆粒培養(yǎng)基
- 標(biāo)準(zhǔn)菌株生化鑒定試劑盒
- 預(yù)灌裝即用型成品培養(yǎng)基
- 2025年版中國(guó)藥典
- 促銷/特價(jià)商品
- 院感/疾控/體外診斷/采樣管
- 樣品采集與處理(均質(zhì))產(chǎn)品
- 按標(biāo)準(zhǔn)檢索培養(yǎng)基
- 模擬灌裝用培養(yǎng)基
- 干燥粉末培養(yǎng)基
- 培養(yǎng)基添加劑/補(bǔ)充劑
- 生化反應(yīng)鑒定管
- 染色液等配套產(chǎn)品
- 對(duì)照培養(yǎng)基/標(biāo)準(zhǔn)品
- 實(shí)驗(yàn)耗材與器具
- 生化試劑/化學(xué)試劑
- 菌種鑒定服務(wù)
圖片中心
您現(xiàn)在的位置: 網(wǎng)站首頁 >> 圖片中心